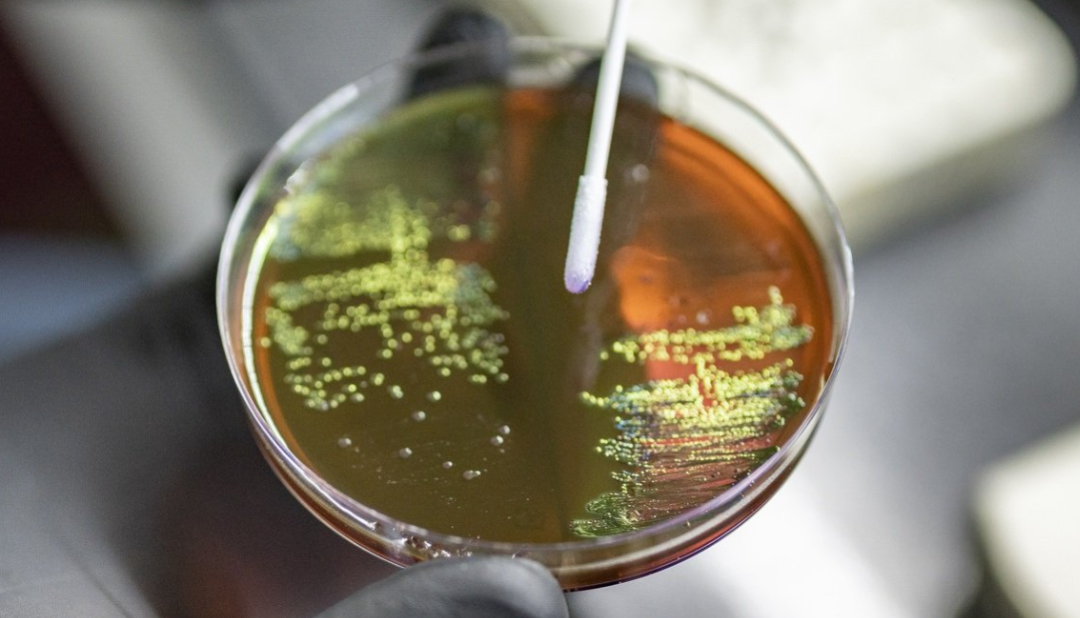

世卫组织发布新报告掌牛宝,警告称全球普遍存在常用抗生素耐药性。
若不尽快采取行动,到2050年耐药菌感染可能导致3900万人丧生,并造成每年高达4120亿美元的经济损失。

抗生素耐药性已成为当今全球健康最严峻的威胁之一,它不仅削弱了我们治疗感染和提供安全医疗救治的能力,更危及世界各地的每个人,其中儿童群体尤为脆弱。
若不尽快采取行动,到2050年耐药菌感染可能导致3900万人丧生,并造成每年高达4120亿美元的经济损失。
虽然抗生素耐药是自然演化过程,但可预防的人类行为正在加速这一危机,主要包括:抗菌药物的误用和滥用;薄弱的感染防控体系;以及环境卫生污染(包括固体垃圾、水源与污水管理不善)。
昨日,世界卫生组织(世卫组织)发布了《2025年全球抗生素耐药性监测报告》,来自100多个国家向世卫组织全球抗微生物药物耐药性和使用监测系统报告的数据表明:救命药物的耐药率已处于危险高位且持续攀升,尤其在资源有限地区更为严重。
报告指出,2023年全球范围内导致常见感染的实验室确诊细菌感染中,有六分之一对抗生素治疗耐药。2018年至2023年期间,超过40%的受监测抗生素的耐药性出现上升,年均增幅达5%至15%。
这份新的《2025年全球抗生素耐药性监测报告》首次公布了用于治疗泌尿道和胃肠道感染、血流感染以及淋病的22种抗生素的耐药率估计值。报告涵盖了8种常见的细菌病原体——鲍曼不动杆菌、大肠杆菌、、淋病奈瑟菌、非伤寒沙门菌、志贺菌、金黄色葡萄球菌和肺炎链球菌——每种病原体均与上述一种或多种感染相关。
抗生素耐药性风险在世界各地存有差异
世卫组织估计,抗生素耐药性在世卫组织东南亚区域和东地中海区域最高,这两个区域报告的感染中有三分之一表现出耐药性。在非洲区域,五分之一的感染存在耐药性。在卫生系统缺乏诊断或治疗细菌病原体能力的地方,耐药性也更为普遍且日趋严重。

世卫组织总干事谭德塞博士说:“抗微生物药物耐药性的发展速度超过了现代医学的进步,威胁着全世界家庭的健康。随着各国加强抗微生物药物耐药性监测体系,我们必须负责任地使用抗生素,并确保人人都能获得正确的药物、有质量保证的诊断工具和疫苗。我们的未来还取决于加强预防、诊断和治疗感染的体系掌牛宝,以及开发新一代抗生素和快速即时分子检测法。”
革兰氏阴性菌病原体构成最大威胁
这份新报告指出,耐药的革兰氏阴性菌正在世界范围内变得愈加危险,而应对能力最弱的国家承受的负担最重。
其中,大肠杆菌和肺炎克雷伯菌是在血流感染中发现的主要耐药革兰氏阴性菌。这些属于最严重的细菌感染,常导致败血症、器官衰竭和死亡。
然而,全球范围内超过40%的大肠杆菌和超过55%的肺炎克雷伯菌目前已对治疗这些感染的首选药物——第三代头孢菌素产生耐药性。在非洲区域,这一比例甚至超过70%。
其他基本的救命抗生素,包括碳青霉烯类和氟喹诺酮类药物,对大肠杆菌、肺炎克雷伯菌、沙门菌和不动杆菌的效力正在下降。碳青霉烯类耐药曾经很罕见,现在正变得越来越常见,导致治疗选择受限,并迫使人们依赖属于“最后防线”的抗生素。而此类抗生素价格昂贵、难以获得,并且在低收入和中等收入国家往往无法供应。
抗微生物药物耐药性监测取得可喜进展——但仍需加大行动力度
参与全球抗微生物药物耐药性和使用监测系统的国家数量从2016年的25个增加到2023年的104个,增长超过四倍。
然而,2023年有48%的国家未向该系统报告数据,并且约半数报告国仍缺乏生成可靠数据的系统。
事实上,面临最大挑战的国家往往缺乏评估本国抗微生物药物耐药性情况的监测能力。
2024年联合国大会通过的《抗微生物药物耐药性问题政治宣言》设定了通过加强卫生系统和采用统筹人类健康、动物健康和环境部门的“同一健康”方针来解决抗微生物药物耐药性问题的目标。
为应对日益严峻的抗微生物药物耐药性挑战,各国必须承诺加强实验室系统,生成可靠的监测数据,特别是来自服务不足地区的数据,以便为治疗和政策提供依据。
世卫组织呼吁所有国家在2030年前向全球抗微生物药物耐药性和使用监测系统报告高质量的抗微生物药物耐药性和使用数据。
实现这一目标需要采取一致行动,加强抗微生物药物耐药性监测数据的质量、地理覆盖范围和共享,以跟踪进展。
各国应加大旨在解决各级医疗体系中抗微生物药物耐药性问题的协调干预,并确保治疗指南和基本药物清单与本地耐药性模式相符。
随报告一同发布的还有扩展数字内容,可通过世卫组织的全球抗微生物药物耐药性和使用监测系统看板查阅。
该看板提供全球和区域情况汇总、基于未调整监测覆盖率和抗微生物药物耐药性数据的国家概况,以及关于抗微生物药物使用的详细信息。
中国已通过《遏制微生物耐药国家行动计划》多措并举应对这一挑战,着力加强感染预防控制、监测体系和抗菌药物合理使用。
每个人都能为减少抗生素耐药出一份力——通过勤洗手、接种疫苗、仅在合格医务人员开具处方时使用抗生素、避免人畜不必要的药物使用——我们就可以共同守护健康,守护救命药物的有效性。
来源:世界卫生组织
*“医学界”力求所发表内容专业、可靠,但不对内容的准确性做出承诺;请相关各方在采用或以此作为决策依据时另行核查。
哈福配资提示:文章来自网络,不代表本站观点。